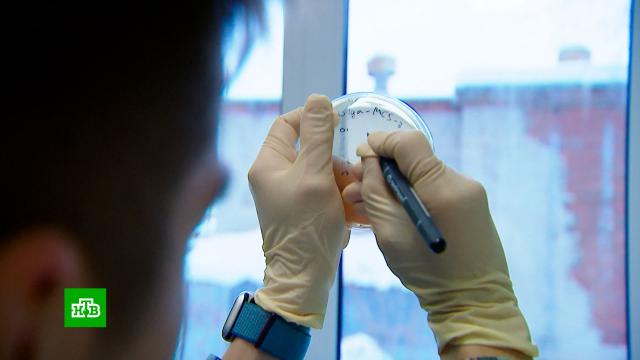

В Новосибирске ученые готовят первые в России ксенотрансплантации. Это пересадка органов от свиней к человеку. Цель проекта − преодолеть острый дефицит донорского материала. Подобные эксперименты в мире уже проводили. Но проблема в том, что иммунитет человека отторгает чужеродные органы. Сибирские генетики придумали, как этого избежать.
Сибирские ученые готовят почву для первых ксенотрансплантаций в России — это пересадка органов от другого биологического вида. В Новосибирской области в 2024 году врачи провели порядка 100 операций по трансплантации органов от человека к человеку. Для региона это много, но не максимум возможностей. Препятствие, по сути, одно.
Нариман Баттулин, руководитель лаборатории генетики и развития Института цитологии и генетики СО РАН: «Органов сильно не хватает. Это факт, что большая часть людей в списках на трансплантацию не дожидаются органов. И фактически единственный прорывной способ
Дальше всего в ксенотрансплантации продвинулись Китай и США. Но успешных опытов по пальцам пересчитать — органы отторгаются. Последний рекорд — 9 месяцев, столько пересаженная от свиньи почка прослужила американцу Тиму Эндрюсу. Для ученых всего мира это обнадеживающий результат. В Новосибирске есть всё для отработки технологии: экспериментальная площадка, большой опыт трансплантаций и модификации генов.
Эдуард Чуйко, ведущий эмбриолог проекта по ксенотрансплантации: «Идея ксенотрансплантации на самом деле простая: вам нужно сделать так, чтобы орган был абсолютно невидим для иммунной системы человека, для этого нам нужно использовать человеческие гены».
Над проектом работает команда молодых исследователей. Их задача — сделать так, чтобы орган свиньи не отторгался организмом человека. С помощью редактирования генома это возможно: удалить часть генов животного, добавить гены человека.
Анна Тархова,
Эдуард Чуйко, ведущий эмбриолог проекта по ксенотрансплантации: «Мы стали первыми в нашей стране, кто смог получить свинью после процедуры эко. До этого у нас в стране такого не было, так что у нас есть абсолютно все технологии, абсолютно вся процедура, которая позволяет этому проекту осуществиться».
Предполагается, что люди смогут получить от свиньи сердце, печень, почки, возможно, легкие и даже кожу на время ожидания своего донора или дольше. Никаких человеческих черт вопреки опасениям поклонников теорий заговора у
Команда проекта ожидает, что через